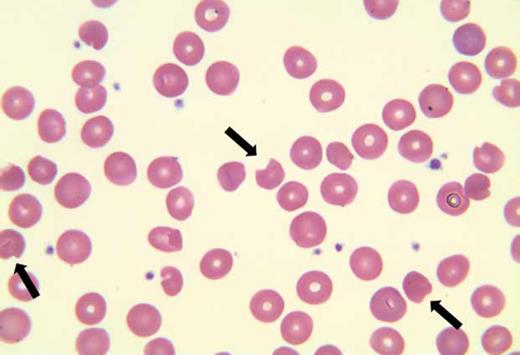
Peripheral blood smear for Bite Cells Abound image challenge. / Peripheral blood smear.

A 61-year-old woman presented to clinic with fatigue, weakness, and dark urine. She underwent renal transplantation two months prior and was taking sirolimus, azathioprine, and prednisone 7.5 mg daily for immunosuppression, as well as dapsone 50 mg daily for Pneumocystis jirovecii pneumonia (PJP) prophylaxis. Glucose-6-phosphate dehydrogenase (G6PD) enzymatic activity was previously normal (15.3 U/g hemoglobin). Laboratory evaluation is shown in the Table. Ultrasound of the transplanted kidney was unremarkable. Peripheral blood smear (shown) revealed anisocytosis, frequent degmacytes (bite cells, arrows), occasional dacrocytes, and rare schistocytes (0-1/hpf).
| Test . | Result at Baseline . | Result at Presentation . | Reference Range . |
|---|---|---|---|
| White blood cell count | 10.04 × 109/L | 8.73 × 109/L | 4.00-11.00 k/µL |
| Hemoglobin | 12.3 g/dL | 7.0 g/dL | 12.0-16.0 g/dL |
| MCV | 93.4 | 103.9 | 83.0-95.0 fL |
| Platelet count | 357 × 109/L | 210 × 109/L | 150-450 × 109/L |
| LDH | 419 U/L | 125-250 U/L | |
| Haptoglobin | <8 mg/dL | 30-200 mg/dL | |
| Reticulocytes | 2.37% | 5.67% | 0.70-2.50% |
| Direct antiglobulin (Coombs) test | Negative | ||
| AST | 26 U/L | 45 U/L | 15-37 U/L |
| ALT | 40 U/L | 39 U/L | 13-61 U/L |
| Creatinine | 1.0 mg/dL | 0.7 mg/dL | 0.6-1.3 mg/dL |
| Total bilirubin | 2.7 mg/dL | 7.0 mg/dL | 0.2-1.0 mg/dL |
| Direct bilirubin | 0.4 mg/dL | 0.0-0.5 mg/dL | |
| Folic acid | 17.8 ng/dL | 7.0-31.1 ng/dL | |
| Cytomegalovirus viral load | Negative | ||
| Epstein Barr virus viral load | Negative | ||
| TPMT | Negative |
| Test . | Result at Baseline . | Result at Presentation . | Reference Range . |
|---|---|---|---|
| White blood cell count | 10.04 × 109/L | 8.73 × 109/L | 4.00-11.00 k/µL |
| Hemoglobin | 12.3 g/dL | 7.0 g/dL | 12.0-16.0 g/dL |
| MCV | 93.4 | 103.9 | 83.0-95.0 fL |
| Platelet count | 357 × 109/L | 210 × 109/L | 150-450 × 109/L |
| LDH | 419 U/L | 125-250 U/L | |
| Haptoglobin | <8 mg/dL | 30-200 mg/dL | |
| Reticulocytes | 2.37% | 5.67% | 0.70-2.50% |
| Direct antiglobulin (Coombs) test | Negative | ||
| AST | 26 U/L | 45 U/L | 15-37 U/L |
| ALT | 40 U/L | 39 U/L | 13-61 U/L |
| Creatinine | 1.0 mg/dL | 0.7 mg/dL | 0.6-1.3 mg/dL |
| Total bilirubin | 2.7 mg/dL | 7.0 mg/dL | 0.2-1.0 mg/dL |
| Direct bilirubin | 0.4 mg/dL | 0.0-0.5 mg/dL | |
| Folic acid | 17.8 ng/dL | 7.0-31.1 ng/dL | |
| Cytomegalovirus viral load | Negative | ||
| Epstein Barr virus viral load | Negative | ||
| TPMT | Negative |
Abbreviations: ALT, alanine aminotransferase; AST, aspartate aminotransferase; LDH, actate dehydrogenase; MCV, mean cell volume; TPMT, thiopurine methyltransferase genetics.
Peripheral blood smear for Bite Cells Abound image challenge
Peripheral blood smear.
Peripheral blood smear.
A. Immune-mediated hemolysis
B. Oxidative stress-induced hemolysis
C. Bone marrow suppression
D. Nutritional deficiency
E. Thrombotic microangiopathy
Sorry, that was not the preferred response.
Correct!
The clinical picture is most consistent with dapsone-induced hemolytic anemia. Dapsone is an antimicrobial often used in immunosuppressed patients to prevent PJP. Hemolysis related to dapsone and its metabolites results from oxidative stress on red blood cell membranes leading to cell breakdown.1 Due to the increased risk of severe hemolytic anemia in G6PD-deficient patients treated with dapsone, determining serum G6PD activity is routine prior to drug initiation.2 This case highlights that dapsone-induced hemolysis can be seen even in the absence of G6PD deficiency and should remain on the differential diagnosis in patients with normal G6PD levels.
Her symptoms and laboratory evaluation were consistent with hemolytic anemia as evidenced by decreased hemoglobin, elevated LDH, reticulocytosis, undetectable haptoglobin, and dark urine. A negative direct antiglobulin test (or direct Coombs test) points away from an autoimmune etiology. Microangiopathic hemolytic anemia is unlikely given the lack of significant red cell fragmentation, thrombocytopenia, or acute kidney injury. The presence of bite cells on her peripheral blood smear, although not necessary for the diagnosis, supports an oxidative stress-mediated hemolytic anemia secondary to dapsone.
After dapsone was discontinued, hemoglobin, haptoglobin, and LDH normalized, and clinical symptoms improved.
References
References
Dr. Shantzer and Dr. Davidson indicated no relevant conflicts of interest.